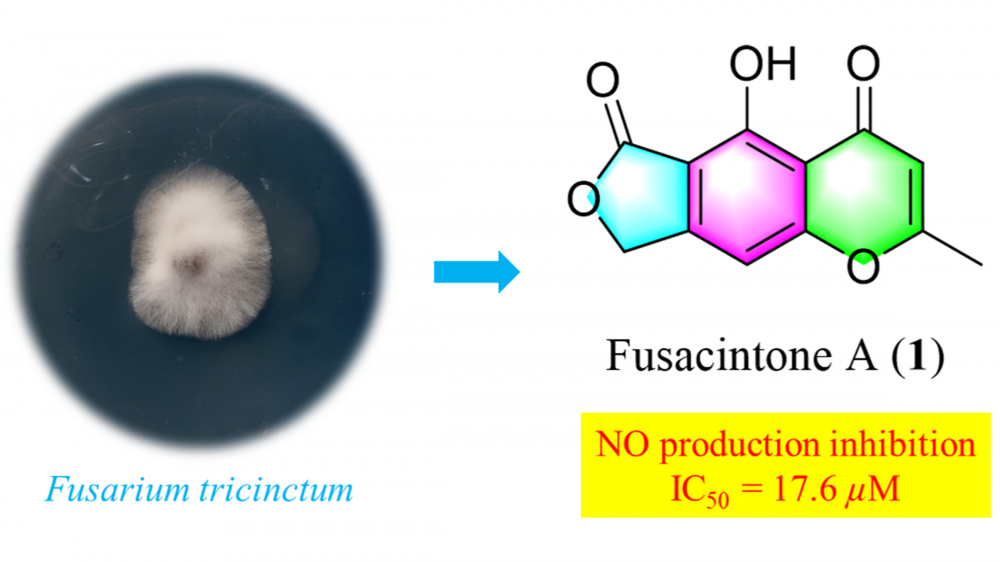

Records of Natural Products
A scientific open access journal in the field of natural products.LATEST ARTICLES
Trichothecene Sesquiterpenes with Anti-osteosarcoma Cytotoxicity from the Fungus Fusarium sp. XPW68

Fusarinene A (1), a previously undescribed trichothecene sesquiterpene, and three known compounds, 4β-hydroxytrichotheca-9,12-diene (2), trichodermol (3), and trichodermin (4), were isolated from the extract of Fusarium sp. XPW68. Their structures and relative configurations were identified by detailed analysis of nuclear magnetic resonance (NMR) and high-resolution electrospray ionization mass spectrometry (HRESIMS) data. In the cytotoxic assay, compounds 1-4 exhibited selective or potent inhibition against five human osteosarcoma cell lines including 143B, MG-63, SaOS-2, SW1353, and U2OS, with IC50 values ranging from 0.8 to 48.2 μM.
DOI http://doi.org/10.25135/rnp.519.25.04.3479 Keywords Fusarium trichothecene sesquiterpene structure elucidation cytotoxic activity Available online: May 22, 2025 DETAILS DOWNLOAD PDF © ACG Publications. All rights reserved.
Enzyme Inhibition Properties of Calendula officinalis, Matricaria chamomilla, and Anthemis pseudocotula: Kinetics and Molecular Docking Studies

This study determined the enzyme inhibition potential of three species (Calendula officinalis, Matricaria chamomilla, and Anthemis pseudocotula) from the Asteraceae family through in silico, followed by in vitro studies. Quinic acid, fumaric acid, gallic acid, chlorogenic acid, vanillic acid, quercetin, apigenin, and isorhamnetin were determined by LC-MS/MS in all of the species. Metabolic enzymes are essential catalysts regulating biochemical reactions within living organisms, facilitating energy production, detoxification, and biosynthesis. These enzymes play a crucial role in maintaining cellular homeostasis and are tightly regulated to ensure optimal metabolic function. High docking scores were also obtained for butyrylcholinesterase (BChE), α-glycosidase, α-amylase, and human carbonic anhydrase I and II enzymes (hCA I and hCA II). Among the extracts, Anthemis pseudocotula was concluded to be the best inhibitor for the enzymes, which was further determined by in vitro enzyme inhibition tests. Besides, it was concluded that all extracts showed anti-cholinergic, anti-diabetic, and anti-glaucoma properties. This is the first study determining the enzyme inhibition property of Anthemis pseudocotula and the three species' hCA I and hCA II inhibition activities.
DOI http://doi.org/10.25135/rnp.1505.2412.3383 Keywords Enzyme inhibition Matricaria chamomilla Anthemis pseudocotula Calendula officinalis LC-MS/MS Available online: May 04, 2025 DETAILS DOWNLOAD PDF © ACG Publications. All rights reserved.Antibacterial Evaluation of Matricaria recutita L., Achillea millefolium L. Essential Oil and Tetracycline Combinations in Respect to in vivo Toxicity Data¥

MMatricaria recutita L. and Achillea millefolium L. (Astereacea) aetherolea are among the herbal drug preparations used due to their broad-spectrum antimicrobial effects. The present study aimed to evaluate the in vitro antibacterial activity of M. recutita and A. millefolium oils individually combined with tetracycline. Followed by safety/toxicity evaluation using an in vivo animal alternative experimental model, namely Caenorhabditis elegans. Chemical verification of Pharmacopoeia quality essential oils was performed both by GC-FID and GC-MS systems, simultaneously. β-Caryophyllene (17%), β-pinene (13.2%), camphor (10%), and sabinene (9.7%) were identified as major components for A. millefolium essential oil; whereas, bisabolol oxide A (41.6%), α-bisabolol (19.4%), (E)-β-farnesene (17%), α-bisabolol oxide B (5.2%), α-bisabolon oxide A (5%), chamazulene (1.6%), and germacrene D (1.2%) were determined as major components for M. recutita essential oil, respectively, in line with the international standards. Antibacterial activities of essential oils and tetracycline were evaluated by microdilution methods against the standard pathogenic strains Bacillus cereus NRRL B3711, Corynebacterium striatum ATCC BAA-1293, Streptococcus sanguinis ATCC 10556, Staphylococcus aureus ATCC 700699. Minimal inhibitory concentrations (MIC) were determined followed by the checkerboard combination studies. A. millefolium and M. recutita essential oils showed in vitro inhibitory activity against all tested microorganisms (MIC= 48.7-6250 μg/mL). The oil combinations with tetracycline showed varying inhibitory antibacterial activity, where M. recutita essential oil with tetracycline resulted in synergism against S.aureus. In vivo toxicity tests on C. elegans nematodes resulted in a non-acute toxicity, indicating the relatively safe use of the tetracycline combinations.
DOI http://doi.org/10.25135/rnp.517.2503.3455 Keywords Matricaria recutita L Achillea millefolium L. Caenorhabditis elegans synergy antimicrobial activity. Available online: April 30, 2025 DETAILS DOWNLOAD PDF © ACG Publications. All rights reserved.Fusacintone A, a New Polyketide from the Endophytic Fungus Fusarium tricinctum from Fritillaria monantha
A previously undescribed polyketide (1) and four known compounds (2-5) isolated from the endophytic fungus Fusarium tricinctum from Fritillaria monantha. Compound 1 showed anti-inflammatory activity by inhibiting NO production with an IC50 value of 17.6±0.46 µM.
DOI http://doi.org/10.25135/rnp.514.2503.3464 Keywords Fusarium tricinctum endophytic fungus polyketide structural elucidation anti-inflammatory Available online: April 29, 2025 DETAILS DOWNLOAD PDF © ACG Publications. All rights reserved.